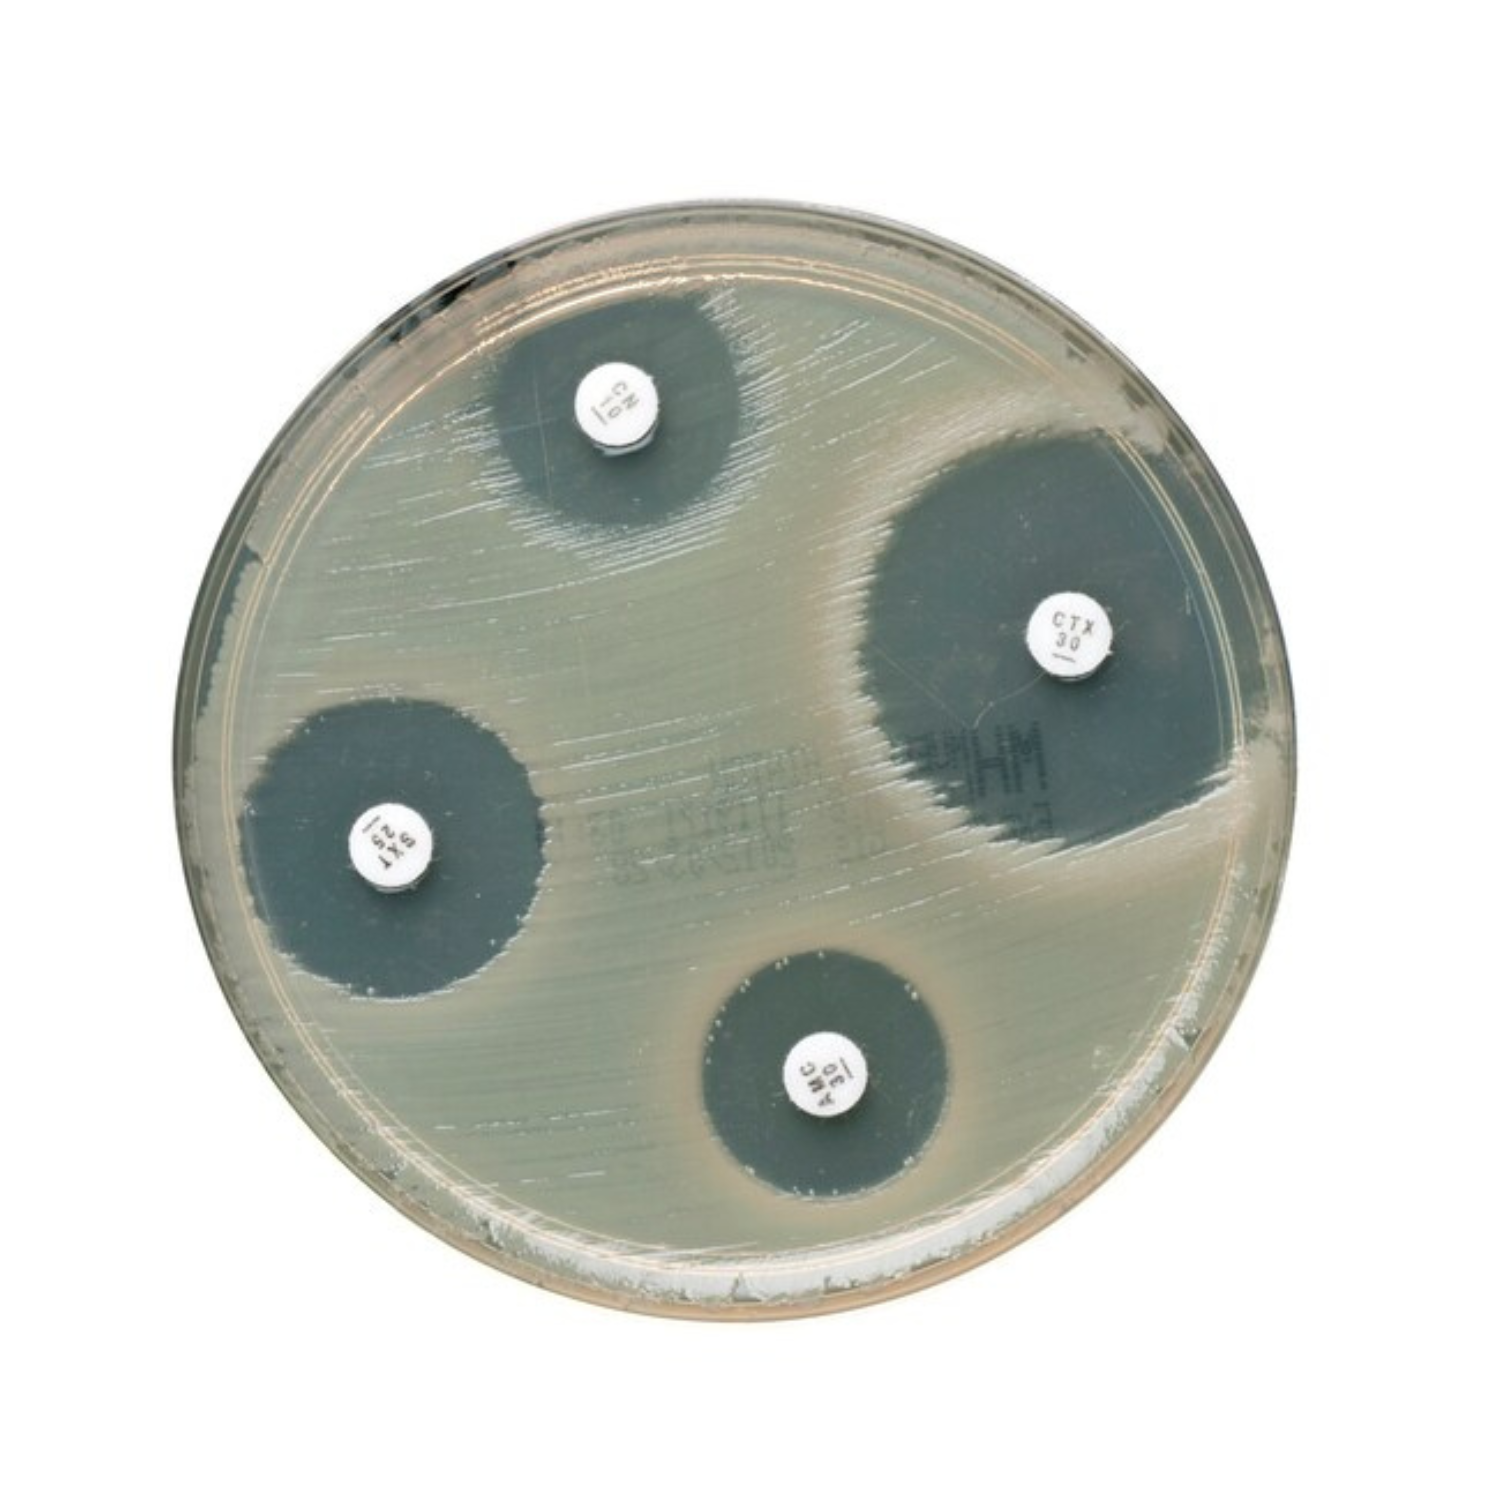
CIPROFLOXACIN 5MCG 5CRT/PK

CIPROFLOXACIN 5MCG 5CRT/PK
Manually determine the antibiotic susceptibility of microorganisms using Antimicrobial Susceptibility Testing (AST) methods in conjunction with reliable, easy-to-use Thermo Scientific™ Oxoid™ Ciprofloxacin Antimicrobial Susceptibility discs.
Ease-of-use is provided by shatterproof spring-loaded cartridges, easy-to-read labeling and end-of-cartridge indicators.
disc diffusion not only categorizes resistant, intermediate and sensitive organisms through quantitative results but also provides a visual indication of the following:
- Inoculum level
- Presence of contamination
- Resistant mutants
- Beta-lactamase activity
- Antagonism and synergy between antibiotics
Each cartridge is individually sealed with a desiccant to maintain a moisture level of <2%, ensuring long term stability.
Not all products are available for sale in all territories. Please inquire.
Remel™ and Oxoid™ products are now part of the Thermo Scientific brand, combining powerful manual, semi-automated and fully automated test products and a comprehensive line of media and diagnostic products to offer a complete, end-to-end solution to quickly deliver the products you need and the quality results your laboratory depends on.
SPECIFICATION
- Brand: Oxoid
- Catalog No.: CT0425B
- Antimicrobial Agents: Ciprofloxacin
- Concentration: 5µg
- Antibiotic Code: CIP
- Test Type: Antimicrobial Susceptibility
- Packaging Type: 50 Discs/Cartridge
- Certifications/Compliance: Complies with CLSI, DIN, BSAC, EUCAST guidelines
- Description: Oxoid Ciprofloxacin Antimicrobial Susceptibility Discs
- Product Type: Antimicrobial Susceptibility Discs
- No. per Pack: 5 Cartridges/Pk.
- Quantity: 50 Discs/Cartridge